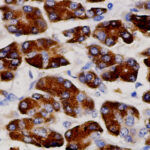
IHC on Pancreas Tissue
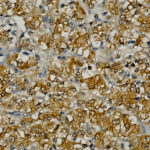
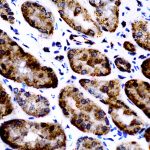
AMA87

|
|---|
 Anti- MYOD1, Clone rMYD712 Anti- MYOD1, Clone rMYD712Buy here |
 Anti- Myosin Heavy chain Anti- Myosin Heavy chainBuy here |
 Anti- Pancreatic Lipase Anti- Pancreatic LipaseBuy here |
 Anti- PAX2 Anti- PAX2Buy here |
 Anti- PSAP, Clone PASE/4LJ Anti- PSAP, Clone PASE/4LJBuy here |
 Anti- Retinoblastoma, Clone 13A10 Anti- Retinoblastoma, Clone 13A10Buy here |
 Anti- SOX-11 Anti- SOX-11Buy here |
 Anti- SPEC1, Clone RBC2/3D5 Anti- SPEC1, Clone RBC2/3D5Buy here |
 Anti- STAT-3, Clone STAT3/2409 Anti- STAT-3, Clone STAT3/2409Buy here |
 Anti- TMPRSS2 Anti- TMPRSS2Buy here |